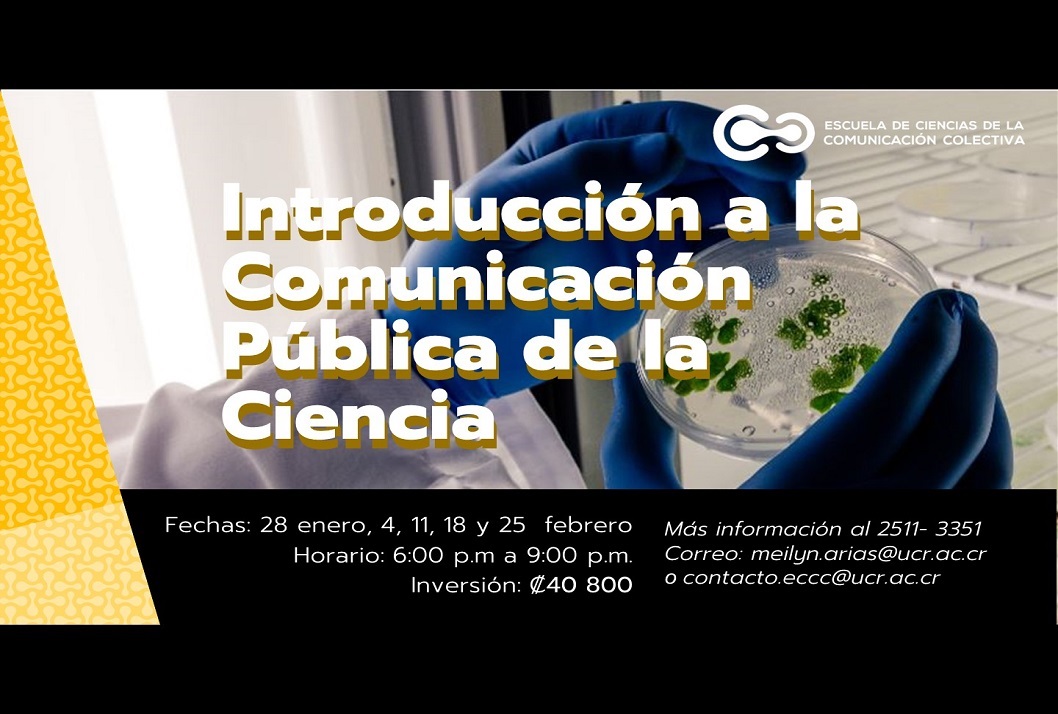

3ENE
Cursos: Programa de capacitación de la Escuela de Administración de Negocios …
Sede Rodrigo Facio (presencial y virtual con alcance nacional)
Matrícula abierta sujeta a un cupo mínimo de participantes

4ENE

4ENE
4ENE
Cursos: Formación de Jefes
Matrícula abierta hasta el lunes 11 de enero en el enlace: https://cutt.ly/4hiFaeb
4ENE
Cursos: Introducción a los Presupuestos Públicos en la Administración Pública de …
Matrícula abierta hasta el lunes 11 de enero en el enlace: https://cutt.ly/ThiFg8s
4ENE
Cursos: Elaboración de Informes de Liquidación Presupuestaria
Matrícula abierta hasta el lunes 11 de enero en el enlace: https://cutt.ly/PhAQn6M
4ENE
Cursos: Administración Efectiva del Tiempo
Matrícula abierta hasta el lunes 11 de enero por medio del enlace: https://cutt.ly/XhAm7J9
5ENE
Cursos: Introducción a la Gestión de Riesgos
Matrícula abierta hasta el lunes 11 de enero en el enlace: https://cutt.ly/xhiDXOi
5ENE
Cursos: Confección de Carteles en la Contratación Administrativa
Matrícula abierta hasta el lunes 11 de enero en el enlace: https://cutt.ly/nhiDaiZ
5ENE
Cursos: Equipo, Comunicación y Colaboración
Matrícula abierta hasta el lunes 11 de enero en el enlace: https://cutt.ly/1hiS3Iz
5ENE
Cursos: Calidad en el Servicio al Cliente con Inteligencia Emocional
Matrícula abierta hasta el lunes 11 de enero en el enlace: https://cutt.ly/2hiSG1R
5ENE
Cursos: Inteligencia Emocional y Asertividad en la Acción del Liderazgo Gerencial
Matrícula abierta hasta el lunes 11 de enero en el enlace: https://cutt.ly/lhiScOj
5ENE
Cursos: Introducción a la Gestión de Proyectos
Matrícula abierta hasta el lunes 11 de enero en el enlace: https://cutt.ly/NhiSt7g
5ENE
Cursos: Liderazgo Situacional Aplicado a la Gerencia
Matrícula abierta hasta el lunes 11 de enero en el enlace:https://cutt.ly/3hiAAtu
5ENE
Cursos: Introducción a la Evaluación
Matrícula abierta hasta el lunes 11 de enero en el enlace: https://cutt.ly/ehiIpfB
5ENE
Cursos: Introducción a la Contratación Administrativa
Matrícula abierta hasta el lunes 11 de enero en el enlace: https://cutt.ly/FhiUVIY
12ENE
Cursos Libres Enero-2021 - Modalidad virtual
Clases virtuales por medio de la plataforma de reuniones Zoom
Matrícula: 12, 13 y 14 de enero, de 9:00 a. m. a 12:00 m. y de 2:00 a 4:00 p. m, por medio de plataforma Zoom: unirse a reunión: https://udecr.zoom.us/j/85326744024 ID: 853 2674 4024 Código de acceso: CL EEG